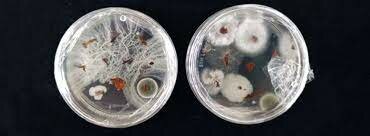
Robert Koch

-
Hooke, el primero en dedicarse a la observación microscópica. descubre las células al observar un pedazo de corcho en el microscopio. Describe los cuerpos de mohos. en su libro "micrographia".
-
diseña microscopio simple con el que observo y describió microorganismos, espermatozoides, bacterias y otros en diferentes sustancias
-
Publicó experimentos en los que demostraba que los gusanos de la carne no eran producto de la putrefacción, poniendo en duda la teoría de la generación espontanea
-
con sus experimentos pone en duda la teoría de la generación espontanea y concluye que la vida solo puede provenir de la vida.
-
Introduce la Viruela de la vaca como una
vacuna de la viruela humana. -
Descubre que la fermentación del acido láctico es causado por un microorganismo
-
Descarta completamente la teoría de la generación espontanea, demostrando que los microorganismos no provienen de la materia inerte.
-
Descubrió que existen distintos tipos de microorganismos con formas y órganos diferentes, éstos los clasificó por ordenaciones sistemáticas.
-
Comprueba que el carbunco es causado por Bacillus anthracis y puede ser cultivada en caldos nutritivos, y que, incluso después de muchas transferencias de cultivo la bacteria podía seguir causando la enfermedad.
-
Desarrolla la vacuna contra el ántrax
-
Cultiva bacterias en gelatina, observando el desarrollo de colonias bacterianas.
-
 Descubre Mycobacterium tuberculosis en muestras de tejido usando azul de metileno y marrón de Marck que teñía solo los tejidos del microorganismo.
Descubre Mycobacterium tuberculosis en muestras de tejido usando azul de metileno y marrón de Marck que teñía solo los tejidos del microorganismo. -
 publica sus cuatro postulados, que son una herramienta hoy en día para determinar las causas de una enfermedad.
publica sus cuatro postulados, que son una herramienta hoy en día para determinar las causas de una enfermedad. -
 Desarrolla la vacuna contra la rabia, cólera aviar y carbunco.
Desarrolla la vacuna contra la rabia, cólera aviar y carbunco. -
demuestra que el parasito de la malaria
es trasmitido por el mosquito, observó que el parásito se estaba acumulando en la glándula salival del mosquito, que contenía el anticoagulante que inyecta antes de alimentarse. -
Formula la técnica de cultivo de enriquecimiento, logrando aislar las bacterias fijadoras de nitrógeno de nódulos de raíces, también aíslo microorganismos como Azotobacter, lactobacillus, algas verdes, entre otras.
Prueba que una partícula viral es el agente causal del mosaico del tabaco.
Descubrió los principios básicos de la Virología. -
 Descubre la penicilina
Descubre la penicilina
Want to make a timeline like this?
Use Timetoast to turn dates, events, milestones, and phases into a clear visual timeline you can build and share. Timetoast is a timeline maker for work, school, research, and stories.